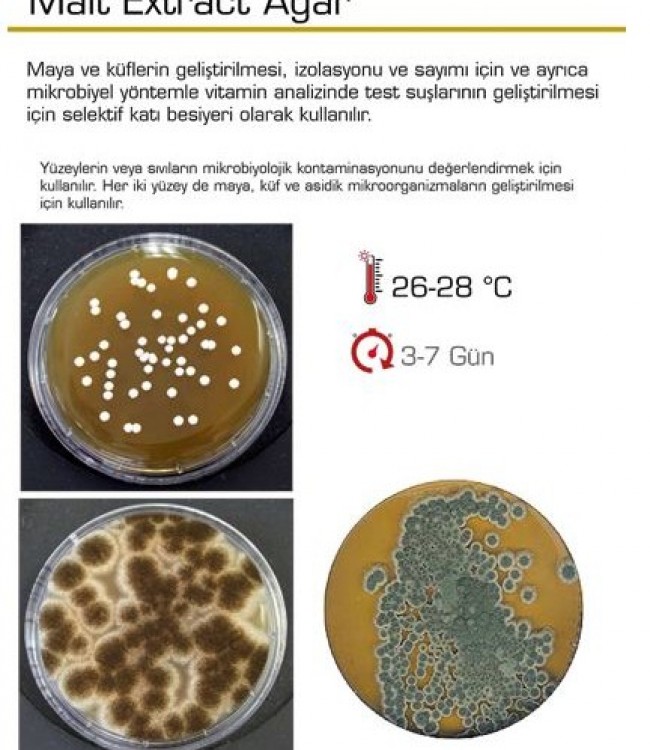
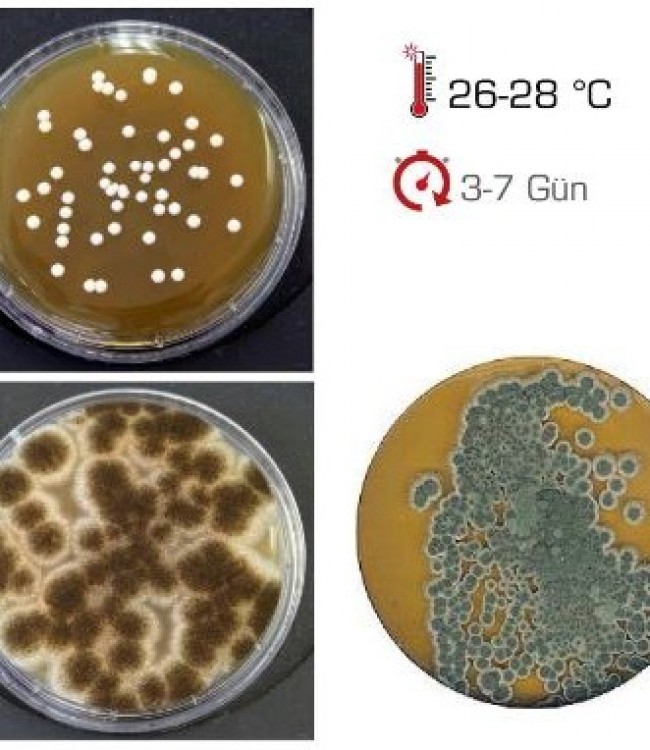
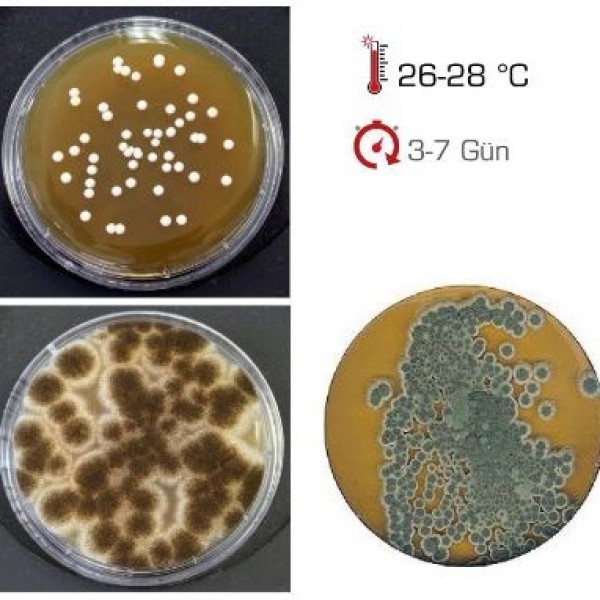

Malt Extract Agar
Malt Extract Agar
Maya ve küflerin geliştirilmesi, izolasyonu ve sayımı için ve ayrıca
mikrobiyel yöntemle vitamin analizinde test suşlarının geliştirilmesi
için selektif katı besiyeri olarak kullanılır.
Yüzeylerin veya sıvıların mikrobiyolojik kontaminasyonunu değerlendirmek için
kullanılır.
Her iki yüzey de maya, küf ve asidik mikroorganizmaların geliştirilmesi
için kullanılır.